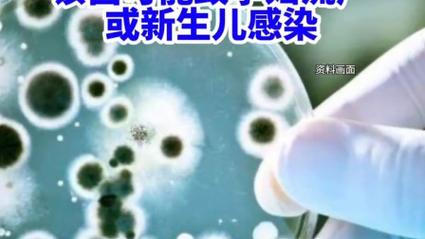

知名熟食肉品牌产品导致李斯特菌疫情爆发!
综合美国中文网报道,联邦卫生官员周三表示,知名熟食肉品牌Boar's Head引发的全国性李斯特菌感染已经导致至少9人死亡,该品牌已经在上个月大规模召回受影响的产品。

疾病控制与预防中心(CDC)说,新的食物中毒死亡病例包括南卡罗来纳州的两人,佛州、新墨西哥州、田纳西州和纽约州各有一人。
此前,伊利诺斯州、新泽西州和维吉尼亚州已确认有3人死亡。

在此次疫情中,至少有57人患病并住院治疗。CDC说,疾病报告始于5月底,一直持续到8月。
这是自2011年以来美国最大规模的李斯特菌疫情,Boar's Head已经召回了700多万磅的熟食产品。
据CDC估计,每年约有1600人因李斯特菌食物中毒,其中约260人死亡。感染可能很难确定,因为症状可能会很快出现,也可能在长达10周后才出现。

这种感染对老年人、孕妇或免疫系统较弱的人尤其危险。
马里兰州卫生官员在收集的猪肝肠样本检测出李斯特菌阳性后,发现了这个问题。
Boar 's Head最初召回了7月25日至8月30日期间在零售熟食店售卖的切片猪肝肠和其他产品。
7月29日,召回范围扩大到该公司位于维吉尼亚州的工厂生产的所有食品。

这些产品包括在熟食柜台切片的熟食肉,以及一些预先包装的零售香肠、法兰克福香肠和培根。
该公司在网站上说,所有被召回的熟食肉都已从商店下架,不再供应。
农业部官员说,这些产品此前被分发到全国各地的商店,以及开曼群岛、多米尼加共和国、墨西哥和巴拿马。

CDC敦促消费者检查他们的冰箱是否有被召回的产品。被召回产品的标签上有农业部检验标志EST. 12612或P-12612,其中一些产品的销售日期最晚到10月。
CDC表示,购买了被召回产品的消费者应该丢弃该食品,彻底清洁和消毒冰箱和其他接触过的表面。










